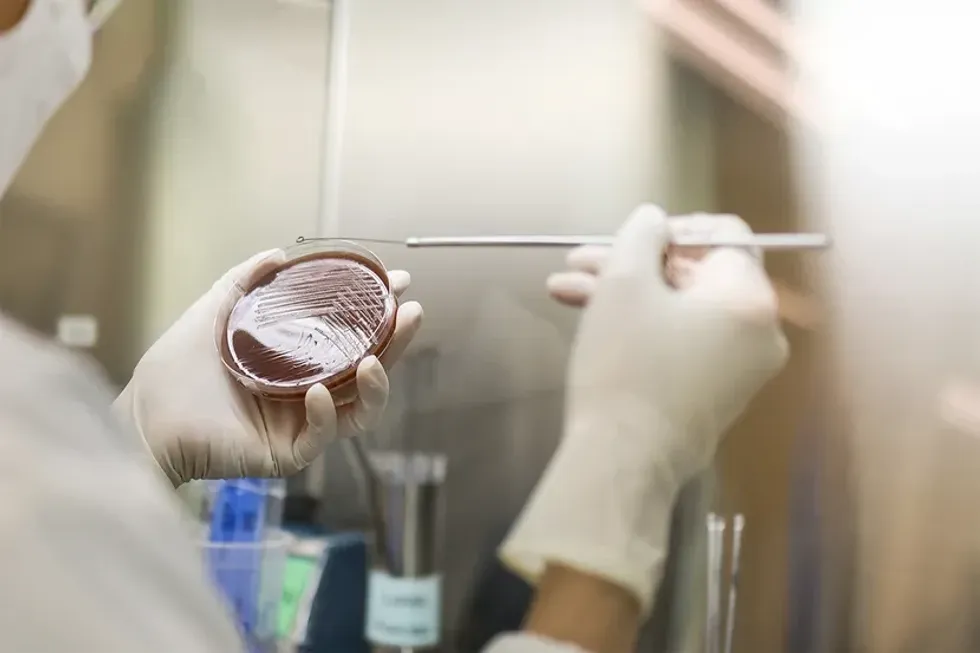

Djegia, kruarja, sekrecioni dhe era e pakëndshme nuk tregojnë gjithmonë të njëjtin problem. Disa simptoma mund të fshehin gjendje që kërkojnë trajtim krejt tjetër
Kruarja, djegia, irritimi, sekrecioni i dendur vaginal dhe aroma e pakëndshme janë simptoma të shpeshta të infeksionit vaginal mykotik, vaginozës bakteriale, por edhe të alergjive dhe irritimeve nga produktet agresive të higjienës. Infeksioni vaginal mykotik zakonisht shkaktohet nga shumimi i tepërt i kërpudhave, më së shpeshti Candida. Edhe pse zakonisht është i padëmshëm, simptomat e tij mund të ngjajnë me sëmundje seksualisht të transmetueshme ose me sëmundje të lëkurës si psoriaza.
Simptoma të ngjashme, trajtim i ndryshëm
Është e mundur që të kemi gonorre dhe klamidia, e jo vetëm infeksion vaginal mykotik, paralajmërojnë mjekët. Simptomat e ngjashme nuk duhet të jenë arsye për vetëdiagnozë. Nëse shqetësimet përsëriten shpesh ose nuk janë tipike, nevojitet kontroll mjekësor dhe diagnozë e saktë.
Shumë shqetësime vaginale mund të kenë simptoma të ngjashme, por të kërkojnë trajtim të ndryshëm.
Infeksioni vaginal mykotik shkakton djegie, kruarje, sekrecion të dendur, të bardhë, të ngjashëm me djathin dhe parehati në regjionin gjenital. Shumë gjendje të tjera mund t’i ngjajnë këtij infeksioni, prandaj është e rëndësishme konsultimi me mjekun, tha Jennifer Nelson, transmeton Telegrafi.
Si duket infeksioni mykotik?
Infeksioni vaginal mykotik zakonisht shkakton: kruarje, irritim, djegie, sekrecion të dendur e të bardhë dhe parehati në regjionin gjenital.
Infeksionet seksualisht të transmetueshme
Infeksionet seksualisht të transmetueshme mund të japin simptoma të ngjashme me infeksionin mykotik.
Këto infeksione mund të shkaktojnë vaginit, pra irritim të vaginës. Simptomat përfshijnë sekrecion vaginal, kruarje, djegie, dhimbje gjatë marrëdhënieve seksuale, gjakderdhje dhe aromë të pakëndshme, thekson Jennifer Nelson.
Infeksionet më të shpeshta janë:
• Trihomoniaza: shpesh pa simptoma, por mund të shkaktojë kruarje, djegie ose sekrecion
• Gonorrea dhe klamidia: shtim të sekrecionit, djegie ose dhimbje në fund të barkut
• Mycoplasma genitalium: sekrecion, gjakderdhje ose dhimbje gjatë marrëdhënies
Zakonisht trajtohen me antibiotikë. Meqë shpesh mund të jenë pa simptoma, kontrollet e rregullta gjinekologjike janë të rëndësishme.
Vaginoza bakteriale
Vaginoza bakteriale është një nga shkaqet më të shpeshta të sekrecionit vaginal dhe shpesh ngatërrohet me infeksionin mykotik.
Është pasojë e çrregullimit të ekuilibrit të baktereve në vaginë. Në vend të baktereve “të mira”, fillojnë të mbizotërojnë baktere të tjera, tha Jennifer Nelson.
Simptomat janë: sekrecion i hollë, në të bardhë dhe erë e pakëndshme si peshk. Zakonisht trajtohet me antibiotikë.
Reaksionet alergjike ose irritimi
Regjioni vaginal është i ndjeshëm dhe mund të reagojë ndaj detergjentëve, sapunëve, losioneve dhe kremrave. Simptomat janë kruarje, djegie dhe sekrecion. Thelbësore është të njihet dhe shmanget irrituesi.
Sëmundjet e lëkurës që prekin vulvën
Ekzema, psoriaza dhe lichen sclerosus mund të japin simptoma të ngjashme. Lihenskleroza shpesh shkakton kruarje të fortë dhe është më e shpeshtë pas menopauzës.
Për shkak të mbivendosjes së simptomave, është vështirë të përcaktohet shkaku pa kontroll mjekësor.
Në përgjithësi, infeksionet mykotike shoqërohen me sekrecion të dendur dhe kruarje intensive, vaginoza bakteriale me sekrecion të hollë dhe erë të pakëndshme, ndërsa te infeksionet seksualisht të transmetueshme mund të ketë dhimbje, gjakderdhje ose sekrecion të pazakontë. Testimi mbetet mënyra më e sigurt për diagnozë. /Telegrafi/
